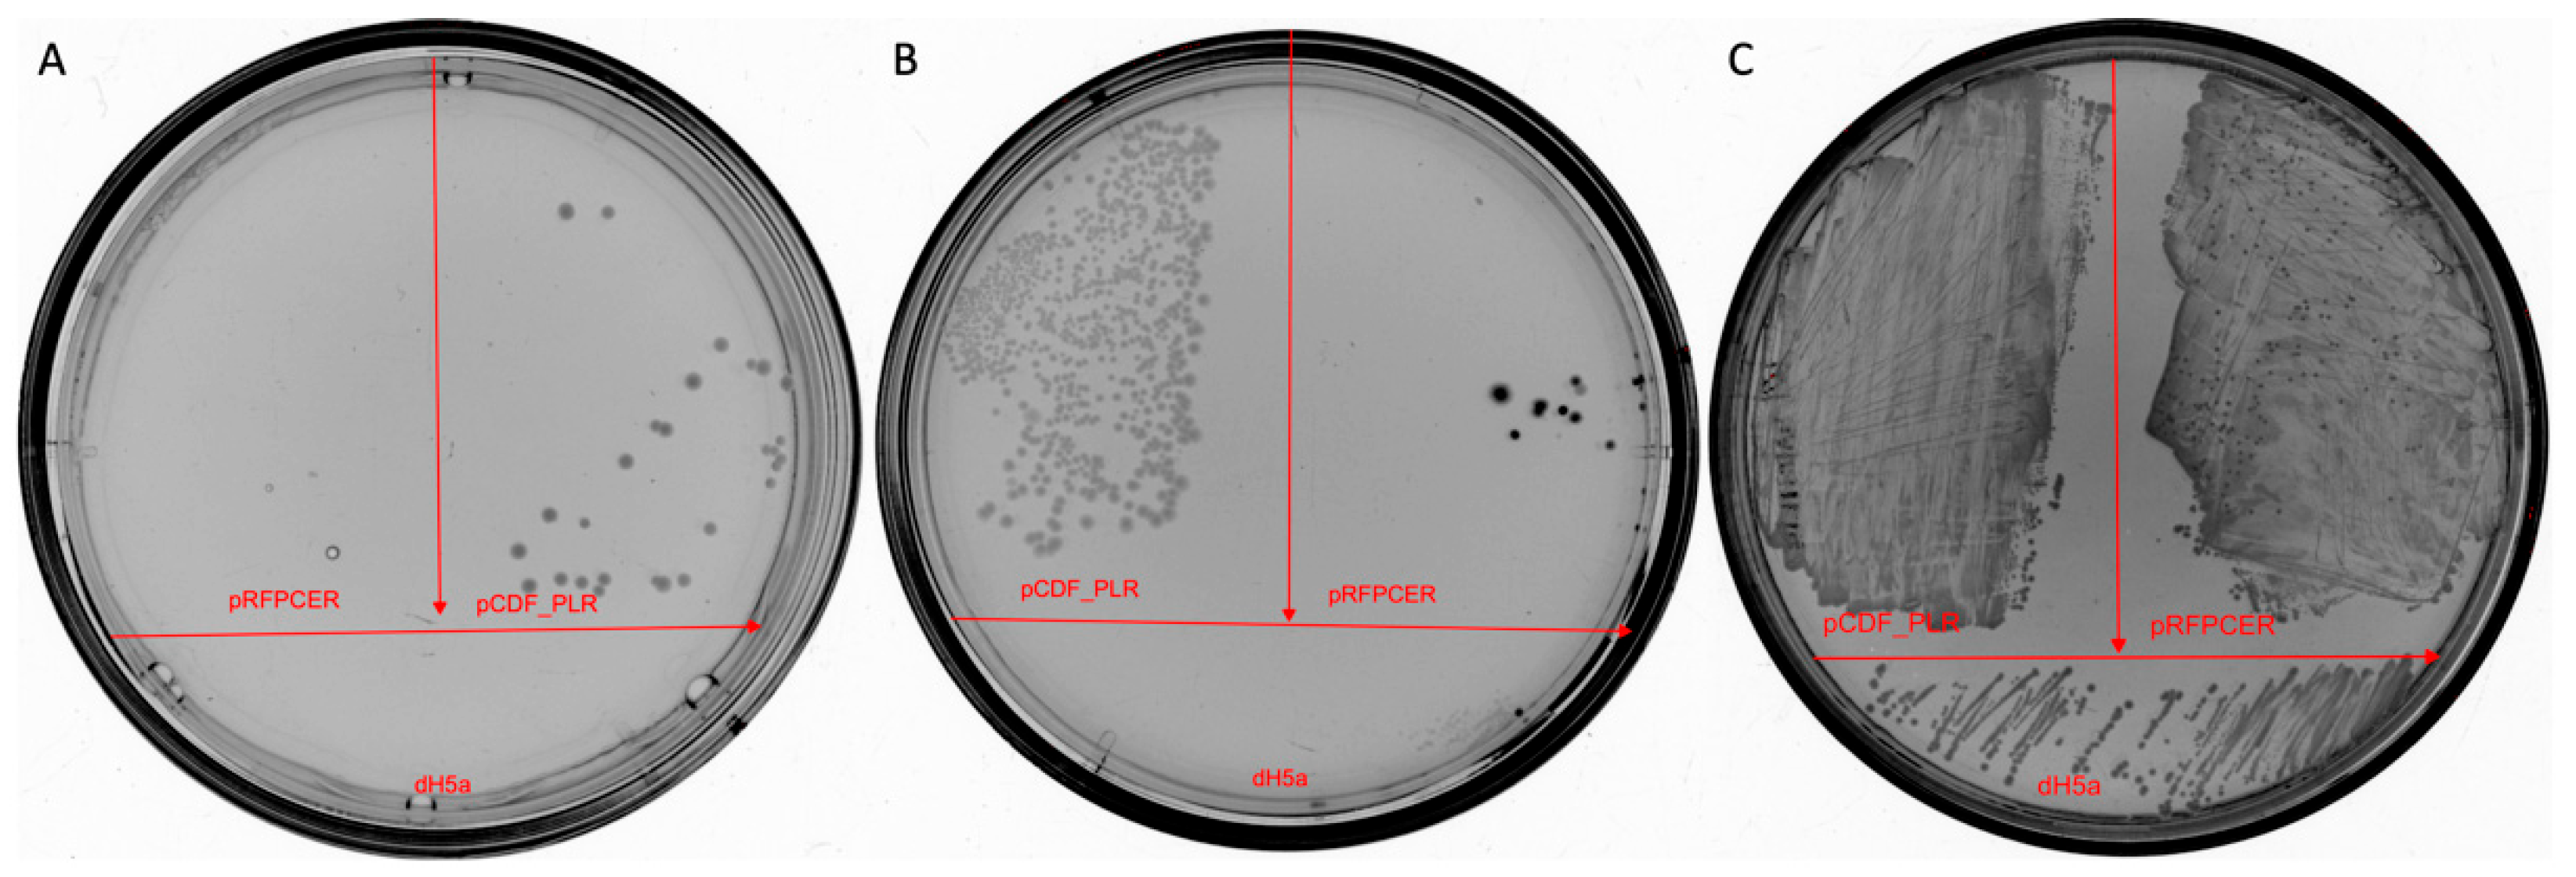
Ijms 25 13328 g009

Novel Selectable Marker Sesquiterpenoid Antibiotic Pentalenolactone
Abstract
1. Introduction
2. Results
2.1. Isolation of Actinobacteria Strains and Screening Antimicrobial Activity
2.2. Genome Features and Phylogenomic Analysis of Streptomyces sp. Strain AP22
2.3. Phenotypic Characterization of Streptomyces sp. Strain AP22
2.4. Identification of the Active Compound and Its Confirmed Mechanism of Action
2.5. Analysis of Streptomyces sp. AP22 Bioactive Compound Biosynthetic Gene Clusters
2.6. Selection of Resistant Clones
2.7. New Resistant Marker Verification
3. Discussion
4. Materials and Methods
4.1. Isolation of Strains
4.2. Screening of the Antimicrobial Potential
4.3. DNA Quality Control After Purification
4.4. Nanopore Sequencing
4.5. Data Analysis
4.6. Phenotypic Characterization
4.7. Purification and Identification of Active Compound in Cultural Broth of AP22
4.8. Determination of Minimal Inhibitory Concentration (MIC)
4.9. Selection of Resistant Clones
4.10. Plasmids and Cloning
5. Conclusions
Author Contributions
Funding
Informed Consent Statement
Data Availability Statement
Acknowledgments
Conflicts of Interest
Appendix A










References
- De Simeis, D.; Serra, S. Actinomycetes: A Never-Ending Source of Bioactive Compounds-An Overview on Antibiotics Production. Antibiotics 2021, 10, 483. [Google Scholar] [CrossRef] [PubMed]
- Barka, E.A.; Vatsa, P.; Sanchez, L.; Gaveau-Vaillant, N.; Jacquard, C.; Klenk, H.P.; Clement, C.; Ouhdouch, Y.; van Wezel, G.P. Taxonomy, Physiology, and Natural Products of Actinobacteria. Microbiol. Mol. Biol. Rev. 2016, 80, 1–43. [Google Scholar] [CrossRef] [PubMed]
- Hutchings, M.I.; Truman, A.W.; Wilkinson, B. Antibiotics: Past, present and future. Curr. Opin. Microbiol. 2019, 51, 72–80. [Google Scholar] [CrossRef] [PubMed]
- Silva, G.D.C.; Kitano, I.T.; Ribeiro, I.A.D.F.; Lacava, P.T. The Potential Use of Actinomycetes as Microbial Inoculants and Biopesticides in Agriculture. Front. Soil Sci. 2022, 2, 833181. [Google Scholar] [CrossRef]
- English, A.R.; Mcbride, T.J.; Lynch, J.E. PA 132, a new antibiotic. II. In vitro and in vivo studies. Antibiot. Annu. 1956, 676–681. [Google Scholar]
- Takeuchi, S.; Ogawa, Y.; Yonehara, H. The structure of pentalenolactone (PA-132). Tetrahedron Lett. 1969, 32, 2737–2740. [Google Scholar]
- Takahashi, Y.; Nakashima, T. Actinomycetes, an Inexhaustible Source of Naturally Occurring Antibiotics. Antibiotics 2018, 7, 45. [Google Scholar] [CrossRef]
- Siddharth, S.; Vittal, R. Evaluation of Antimicrobial, Enzyme Inhibitory, Antioxidant and Cytotoxic Activities of Partially Purified Volatile Metabolites of Marine Streptomyces sp. S2A. Microorganisms. 2018, 6, 72. [Google Scholar] [CrossRef]
- Osterman, I.A.; Komarova, E.S.; Shiryaev, D.I.; Korniltsev, I.A.; Khven, I.M.; Lukyanov, D.A.; Tashlitsky, V.N.; Serebryakova, M.V.; Efremenkova, O.V.; Ivanenkov, Y.A.; et al. Sorting Out Antibiotics’ Mechanisms of Action: A Double Fluorescent Protein Reporter for High-Throughput Screening of Ribosome and DNA Biosynthesis Inhibitors. Antimicrob. Agents Chemother. 2016, 60, 7481–7489. [Google Scholar] [CrossRef]
- Kolmogorov, M.; Bickhart, D.M.; Behsaz, B.; Gurevich, A.; Rayko, M.; Shin, S.B.; Kuhn, K.; Yuan, J.; Polevikov, E.; Smith, T.P.L.; et al. metaFlye: Scalable long-read metagenome assembly using repeat graphs. Nat. Methods 2020, 17, 1103–1110. [Google Scholar] [CrossRef]
- Seemann, T. Prokka: Rapid prokaryotic genome annotation. Bioinformatics 2014, 30, 2068–2069. [Google Scholar] [CrossRef] [PubMed]
- Tamura, K.; Stecher, G.; Kumar, S. MEGA11: Molecular Evolutionary Genetics Analysis Version 11. Mol. Biol. Evol. 2021, 38, 3022–3027. [Google Scholar] [CrossRef] [PubMed]
- Dührkop, K.; Nothias, L.F.; Fleischauer, M.; Reher, R.; Ludwig, M.; Hoffmann, M.A.; Petras, D.; Gerwick, W.H.; Rousu, J.; Dorrestein, P.C.; et al. Systematic classification of unknown metabolites using high-resolution fragmentation mass spectra. Nat. Biotechnol. 2021, 39, 462–471. [Google Scholar] [CrossRef] [PubMed]
- Dührkop, K.; Fleischauer, M.; Ludwig, M.; Aksenov, A.A.; Melnik, A.V.; Meusel, M.; Dorrestein, P.C.; Rousu, J.; Bocker, S. SIRIUS 4: A rapid tool for turning tandem mass spectra into metabolite structure information. Nat. Methods 2019, 16, 299–302. [Google Scholar] [CrossRef]
- Ruttkies, C.; Schymanski, E.L.; Wolf, S.; Hollender, J.; Neumann, S. MetFrag relaunched: Incorporating strategies beyond in silico fragmentation. J. Cheminform. 2016, 8, 3. [Google Scholar] [CrossRef]
- Zhu, D.; Seo, M.J.; Ikeda, H.; Cane, D.E. Genome mining in Streptomyces. Discovery of an unprecedented P450-catalyzed oxidative rearrangement that is the final step in the biosynthesis of pentalenolactone. J. Am. Chem. Soc. 2011, 133, 2128. [Google Scholar] [CrossRef]
- Datsenko, K.A.; Wanner, B.L. One-step inactivation of chromosomal genes in Escherichia coli K-12 using PCR products. Proc. Natl. Acad. Sci. USA 2000, 97, 6640–6645. [Google Scholar] [CrossRef]
- Cane, D.E.; Sohng, J.K. Inhibition of glyceraldehyde-3-phosphate dehydrogenase by pentalenolactone: Kinetic and mechanistic studies. Arch. Biochem. Biophys. 1989, 270, 50–61. [Google Scholar] [CrossRef]
- Mann, K.; Mecke, D. Inhibition of spinach glyceraldehyde-3-phosphate dehydrogenases by pentalenolactone. Nature 1979, 282, 535–536. [Google Scholar] [CrossRef]
- Ikeda, H.; Ishikawa, J.; Hanamoto, A.; Shinose, M.; Kikuchi, H.; Shiba, T.; Sakaki, Y.; Hattori, M.; Omura, S. Complete genome sequence and comparative analysis of the industrial microorganism Streptomyces avermitilis. Nat. Biotechnol. 2003, 21, 526–531. [Google Scholar] [CrossRef]
- Maurer, K.H.; Pfeiffer, F.; Zehender, H.; Mecke, D. Characterization of two glyceraldehyde-3-phosphate dehydrogenase isoenzymes from the pentalenolactone producer Streptomyces arenae. J. Bacteriol. 1983, 153, 930–936. [Google Scholar] [CrossRef] [PubMed]
- Fröhlich, K.U.; Kannwischer, R.; Rüdiger, M.; Mecke, D. Pentalenolactone-insensitive glyceraldehyde-3-phosphate dehydrogenase from Streptomyces arenae is closely related to GAPDH from thermostable eubacteria and plant chloroplasts. Arch. Microbiol. 1996, 165, 179–186. [Google Scholar] [CrossRef] [PubMed]
- Jones GM, T.; Harris, J.I. Glyceraldehyde 3-phosphate dehydrogenase: Amino acid sequence of enzyme from baker’s yeast. FEBS Lett. 1972, 22, 185–189. [Google Scholar] [CrossRef]
- Wei, H.; Movahedi, A.; Yang, J.; Zhang, Y.; Liu, G.; Zhu, S.; Yu, C.; Chen, Y.; Zhong, F.; Zhang, J. Characteristics and molecular identification of glyceraldehyde-3-phosphate dehydrogenases in poplar. Int. J. Biol. Macromol. 2022, 219, 185–198. [Google Scholar] [CrossRef]
- Vestergaard, M.; Frees, D.; Ingmer, H. Antibioticresistance and the MRSA problem. Microbiol. Spectrum. 2019, 7, 1–23. [Google Scholar] [CrossRef]
- Tetzlaff, C.N.; You, Z.; Cane, D.E.; Takamatsu, S.; Omura, S.; Ikeda, H. A Gene Cluster for Biosynthesis of the Sesquiterpenoid Antibiotic Pentalenolactone in Streptomyces avermitilis. Biochemistry 2006, 45, 6179–6186. [Google Scholar] [CrossRef]
- Jumper, J.; Evans, R.; Pritzel, A.; Green, T.; Figurnov, M.; Ronneberger, O.; Tunyasuvunakool, K.; Bates, R.; Žídek, A.; Potapenko, A.; et al. Highly accurate protein structure prediction with AlphaFold. Nature 2021, 596, 583–589. [Google Scholar] [CrossRef]
- Jang, C.W.; Magnuson, T. A novel selection marker for efficient DNA cloning and recombineering in E. coli. PLoS ONE 2013, 8, e57075. [Google Scholar] [CrossRef]
- Sutcliffe, J.G. Nucleotide sequence of the ampicillin resistance gene of Escherichia coli plasmid pBR322. Proc. Natl. Acad. Sci. USA 1978, 75, 3737–3741. [Google Scholar] [CrossRef]
- Hershfield, V.; Boyer, H.W.; Yanofsky, C.; Lovett, M.A.; Helinski, D.R. Plasmid ColEl as a molecular vehicle for cloning and amplification of DNA. Proc. Natl. Acad. Sci. USA 1974, 71, 3455–3459. [Google Scholar] [CrossRef]
- Domingues, S.; Nielsen, K.M.; da Silva, G.J. Various pathways leading to the acquisition of antibiotic resistance by natural transformation. Mob. Genet. Elem. 2012, 2, 257–260. [Google Scholar] [CrossRef] [PubMed]
- Luna, B.M.; Ulhaq, A.; Yan, J.; Pantapalangkoor, P.; Nielsen, T.B.; Davies, B.W.; Actis, L.A.; Spellberg, B. Selectable Markers for Use in Genetic Manipulation of Extensively Drug-Resistant (XDR) Acinetobacter baumannii HUMC1. mSphere 2012, 2, 10–1128. [Google Scholar] [CrossRef] [PubMed]
- McDade, H.C.; Cox, G.M. A new dominant selectable marker for use in Cryptococcus neoformans. Med. Mycol. 2001, 39, 151–154. [Google Scholar] [CrossRef] [PubMed]
- Khrenova, M.G.; Panova, T.V.; Rodin, V.A.; Kryakvin, M.A.; Lukyanov, D.A.; Osterman, I.A.; Zvereva, M.I. Nanopore Sequencing for De Novo Bacterial Genome Assembly and Search for Single-Nucleotide Polymorphism. Int. J. Mol. Sci. 2022, 23, 8569. [Google Scholar] [CrossRef]
- Wick, R.R.; Judd, L.M.; Holt, K.E. Performance of neural network basecalling tools for Oxford Nanopore sequencing. Genome Biol. 2019, 20, 129. [Google Scholar] [CrossRef]
- Zakalyukina, Y.V.; Pavlov, N.A.; Lukianov, D.A.; Marina, V.I.; Belozerova, O.A.; Tashlitsky, V.N.; Guglya, E.B.; Osterman, I.A.; Biryukov, M.V. A New Albomycin-Producing Strain of Streptomyces globisporus subsp. globisporus May Provide Protection for Ants Messor structor. Insects 2022, 13, 1042. [Google Scholar] [CrossRef]

| Culture Attributes | Streptomyces sp. AP22 | Streptomyces scabiei | ||||||||
|---|---|---|---|---|---|---|---|---|---|---|
| ISP2 | ISP3 | ISP4 | ISP5 | ISP6 | ISP2 | ISP3 | ISP4 | ISP5 | ISP6 | |
| Growth | ++ | ++ | +++ | +++ | + | ++ | ++ | ++ | ++ | - |
| Coloration of aerial mycelium | Light gray | Light gray | White | Grey | Colorless | Grey | Grey | White | Grey | Colorless |
| Substrate mycelium coloration Substrate mycelium coloration | Brown | Light yellow | White | Light yellow | Colorless | Black | Colorless | Colorless | Fir green | Colorless |
| Antibiotics | MIC for E. coli SQ110DTC, μg/mL | MIC for E. coli SQ110DTC Resistant Clone, μg/mL |
|---|---|---|
| Pentalenolactone | 25 | 200 |
| Erythromycin | 3.13 | 3.13 |
| Antibiotics | MIC on E. coli DH5α Cells with pCDF_PLR Vector (Mutant gapA), μg/mL | MIC on E. coli DH5α Cells with pCDF_GAPA Vector (WT gapA), μg/mL |
|---|---|---|
| Pentalenolactone | 3200 | 50 |
| Erythromycin | 125 | 125 |
Disclaimer/Publisher’s Note: The statements, opinions and data contained in all publications are solely those of the individual author(s) and contributor(s) and not of MDPI and/or the editor(s). MDPI and/or the editor(s) disclaim responsibility for any injury to people or property resulting from any ideas, methods, instructions or products referred to in the content. |
© 2024 by the authors. Licensee MDPI, Basel, Switzerland. This article is an open access article distributed under the terms and conditions of the Creative Commons Attribution (CC BY) license (https://creativecommons.org/licenses/by/4.0/).
Share and Cite
Nikandrova, A.A.; Petriakova, A.D.; Izzi, A.R.; Petrosyan, G.A.; Tashlitsky, V.N.; Alferova, V.A.; Panova, T.V.; Khrenova, M.G.; Biryukov, M.V.; Zakalyukina, Y.V.; et al. Novel Selectable Marker Sesquiterpenoid Antibiotic Pentalenolactone. Int. J. Mol. Sci. 2024, 25, 13328. https://doi.org/10.3390/ijms252413328
Nikandrova AA, Petriakova AD, Izzi AR, Petrosyan GA, Tashlitsky VN, Alferova VA, Panova TV, Khrenova MG, Biryukov MV, Zakalyukina YV, et al. Novel Selectable Marker Sesquiterpenoid Antibiotic Pentalenolactone. International Journal of Molecular Sciences. 2024; 25(24):13328. https://doi.org/10.3390/ijms252413328
Chicago/Turabian StyleNikandrova, Arina A., Anna D. Petriakova, Anton R. Izzi, Garegin A. Petrosyan, Vadim N. Tashlitsky, Vera A. Alferova, Tatiana V. Panova, Maria G. Khrenova, Mikhail V. Biryukov, Yuliya V. Zakalyukina, and et al. 2024. "Novel Selectable Marker Sesquiterpenoid Antibiotic Pentalenolactone" International Journal of Molecular Sciences 25, no. 24: 13328. https://doi.org/10.3390/ijms252413328
APA StyleNikandrova, A. A., Petriakova, A. D., Izzi, A. R., Petrosyan, G. A., Tashlitsky, V. N., Alferova, V. A., Panova, T. V., Khrenova, M. G., Biryukov, M. V., Zakalyukina, Y. V., Zvereva, M. I., Lukianov, D. A., & Sergiev, P. V. (2024). Novel Selectable Marker Sesquiterpenoid Antibiotic Pentalenolactone. International Journal of Molecular Sciences, 25(24), 13328. https://doi.org/10.3390/ijms252413328

